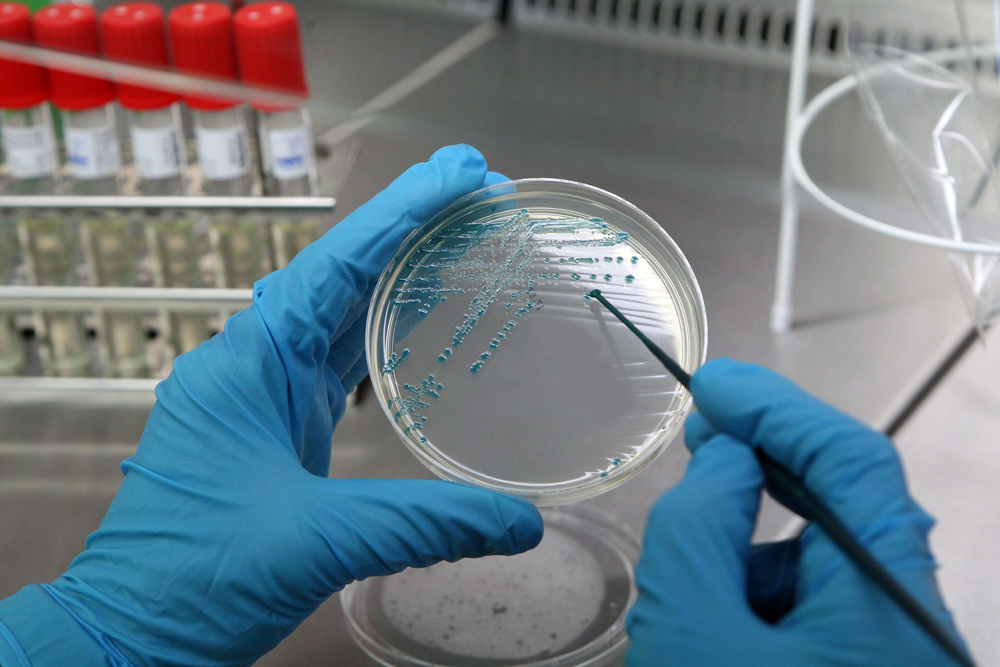
О чём говорит появление диплококков в мазке

Причины, симптомы и методы лечения опущения мочевого пузыря
Опущение мочевого пузыря у женщин может возникнуть по различным причинам. В начальные периоды развития патологического состояния симптоматика весьма скудная. Нередко пациентки не обращают внимания на незначительные нарушения мочеиспускания, которые впоследствии могут серьезно усугубиться. Метод лечения напрямую зависит от своевременности диагностирования заболевания.
При раннем обнаружении патологии проводятся меры по укреплению мышц влагалища и связок органов малого таза. Для этого назначаются физические упражнения и медикаментозная терапия. При риске развития осложнений используют хирургическое вмешательство. При этом методы народной медицины могут быть применены лишь в качестве симптоматического лечения.
Противозачаточные таблетки для женщин от 40 лет
Для женщин в возрасте 40 лет проблема контрацепции так же актуальна, как и для молодых девушек. В этот период существует вероятность нежелательной беременности, несмотря на то, что функции репродуктивной системы постепенно угасают. В настоящее время самым эффективным методом контрацепции является прием противозачаточных таблеток. Защита от беременности при применении оральных контрацептивов составляет 97–99,9%. Но это не единственное их достоинство.
О чём говорит появление диплококков в мазке
Диплококки — разновидность микроорганизмов, деление которых происходит в одной плоскости. Клетки располагаются попарно, имеют бобовидную или ланцетовидную форму. При рассмотрении в обычный световой микроскоп, диплококк напоминает кофейное зерно. К диплококкам относится множество различных видов микроорганизмов, но в клиническом плане наибольший интерес представляют лишь три: S.pneumoniae (возбудитель пневмонии), N.meningitidis (возбудитель менингита) и N.gonorrhoeae (возбудитель гонореи ). Остальные виды могут присутствовать на коже и слизистых оболочках в норме, не вызывая при этом никаких заболеваний.
Иммунограмма: показания, сущность метода, нормальные и патологические значения
Функцией иммунитета является защита организма от всех факторов, способных причинить вред организму, поэтому определение его статуса с использованием метода иммунограммы не теряет своей актуальности. Иммунограмма представляет собой диагностический метод, позволяющий получить представление о состоянии иммунитета человека и способности организма защищаться от воздействия бактериальных и вирусных инфекций. В совокупности с анализом клинической картины и результатов, полученных в ходе других исследований, применяется для диагностики различных заболеваний и патологических состояний. При оценке иммунного статуса учитывается количество обеспечивающих защиту организма элементов, их соотношение и активность.
Неполное опорожнение мочевого пузыря: причины, болезни, лечение
Дискомфортные ощущения, связанные с актом мочеиспускания, представлены симптомами наполнения, опорожнения и постмикционными проявлениями. Частой жалобой пациентов с заболеваниями урогенитальной системы становится ощущение полного мочевого пузыря после похода в туалет. Состояние может быть первым сигналом, указывающим на неблагополучие со стороны здоровья, или предшествовать прогрессированию патологии.
Это Вам пригодится
Противозачаточные таблетки для женщин от 40 лет
Для женщин в возрасте 40 лет проблема контрацепции так же актуальна, как и для молодых девушек. В этот период существует вероятность нежелательной беременности, несмотря на то, что функции репродуктивной системы постепенно угасают. В настоящее время самым эффективным методом контрацепции является прием противозачаточных таблеток. Защита от беременности при применении оральных контрацептивов составляет 97–99,9%. Но это не единственное их достоинство.
Что предлагает банковский кредит под залог квартиры?
Комфортная старость — как ее достичь?
Что делать, когда пропущен прием противозачаточной таблетки: план действий, возможные варианты
Комбинированные оральные контрацептивы (КОК ) обладают надежным противозачаточным действием, многим женщинам они помогают решить проблемы с кожей и волосами, воздействуя на гормональный дисбаланс изнутри. Для достижения необходимого эффекта нужна большая приверженность терапии, пропуск таблетки чреват нежелательной беременностью. Согласно исследованиям фармакологических компаний-производителей КОКов, женщины довольно часто забывают о приеме контрацептива, поэтому специально был разработан алгоритм действий.